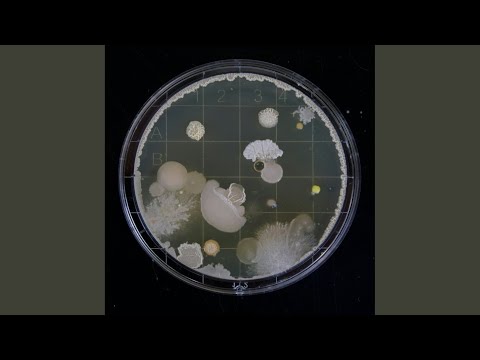

Sleeper Cell
5
Techno
Sleeper Cell wurde am 25. April 2025 von Strictly Essco als Teil des Albums Sleeper Cell - Single veröffentlicht
Melodizität
Wie sehr der Song eine einprägsame Melodie besitzt, die klar definierten musikalischen Mustern folgt. Ein Song mit hohem melodischen Charakter hat in der Regel klare und einprägsame Instrumental- oder Gesangslinien.
Akustizität
Ein Maß dafür, wie sehr ein Lied auf akustische Instrumente (z. B. Klavier, Gitarre, Violine, Schlagzeug, Saxophon) statt auf elektronische oder digital synthetisierte Instrumente angewiesen ist
Valence
Die musikalische Positivität oder der emotionale Ton, der durch die harmonischen und rhythmischen Komponenten des Songs vermittelt wird. Eine hohe Valenz entspricht Gefühlen von Glück, Aufregung und Euphorie, während eine niedrige Valenz mit Traurigkeit, Wut oder Melancholie verbunden ist.
Tanzbarkeit
Eine Kombination aus Faktoren wie Tempostabilität, rhythmischen Mustern und Taktbetonung bestimmt, wie gut ein Song zum Tanzen geeignet ist. Ein „tanzbarer“ Song zeichnet sich durch ein gleichmäßiges Tempo, eine sich wiederholende musikalische Struktur und starke Betonungen aus.
Energie
Die wahrgenommene Intensität eines Titels, die durch Tempo, Dynamik und musikalische Kompaktheit beeinflusst werden kann. Ein energiegeladener Song zeichnet sich durch einen treibenden Rhythmus und eine dichte Instrumentierung aus, während ein energiearmer Song musikalisch spärlicher gestaltet sein und langsamere Tempi aufweisen kann.
BPM127
Musikvideo
Musikvideo
Credits
PERFORMING ARTISTS
Essco
Performer
COMPOSITION & LYRICS
Saul Cohen
Songwriter
PRODUCTION & ENGINEERING
Saul Cohen
Producer